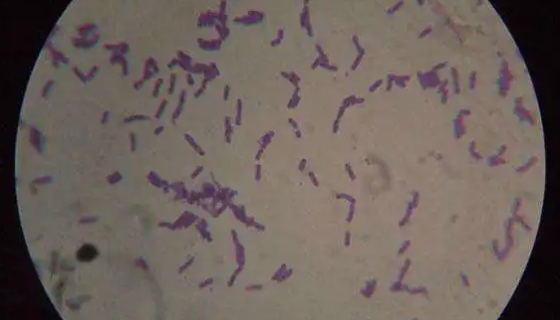
积磷小月菌的特点与优势及培养操作步骤！
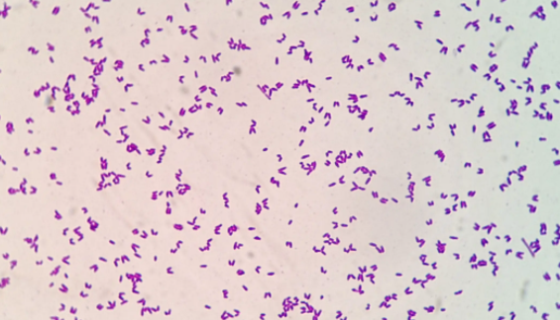
用于生产L-精氨酸的：谷氨酸棒状杆菌（黄色短杆菌）

积磷小月菌的特点与优势及培养操作步骤!
积磷小月菌的知识介绍与产品优势及培养方法与注意事项!

大鼠牙髓干细胞的复苏与传代及冻存操作说明!
大鼠牙髓干细胞取自雄性SD大鼠,仅用于科学研究或者工业应用等...

根癌土壤杆菌——植物遗传工程菌
根癌土壤杆菌,寄主范围非常广,有几百个属,所有苗木都必须检验...

人骨髓增生异常综合征细胞的培养与收货处理方法!
MUTZ-1人骨髓增生异常综合征细胞仅用于科学研究或者工业应...

天蓝吸水链霉菌的使用范围与实验内容及操作方法!
天蓝吸水链霉菌用于实验和科研检测用,属于菌株类。

肠沙门氏菌肠亚种肠炎血清型冻干管打管说明书!
肠沙门氏菌肠亚种肠炎血清型是Salmonella属的微生物,...

ATCC 19171 溶纤维丁酸弧菌 百欧博伟生物
溶纤维丁酸弧菌,细胞由几根极生或亚极生鞭毛运动;尽管培养物中...

小鼠神经细胞收到后的处理与使用方法及培养步骤!
小鼠神经细胞仅用于科学研究或者工业应用等非医疗目的不可用于人...
用于生产L-精氨酸的:谷氨酸棒状杆菌(黄色短杆菌)
谷氨酸棒状杆菌(Corynebacterium glutam...